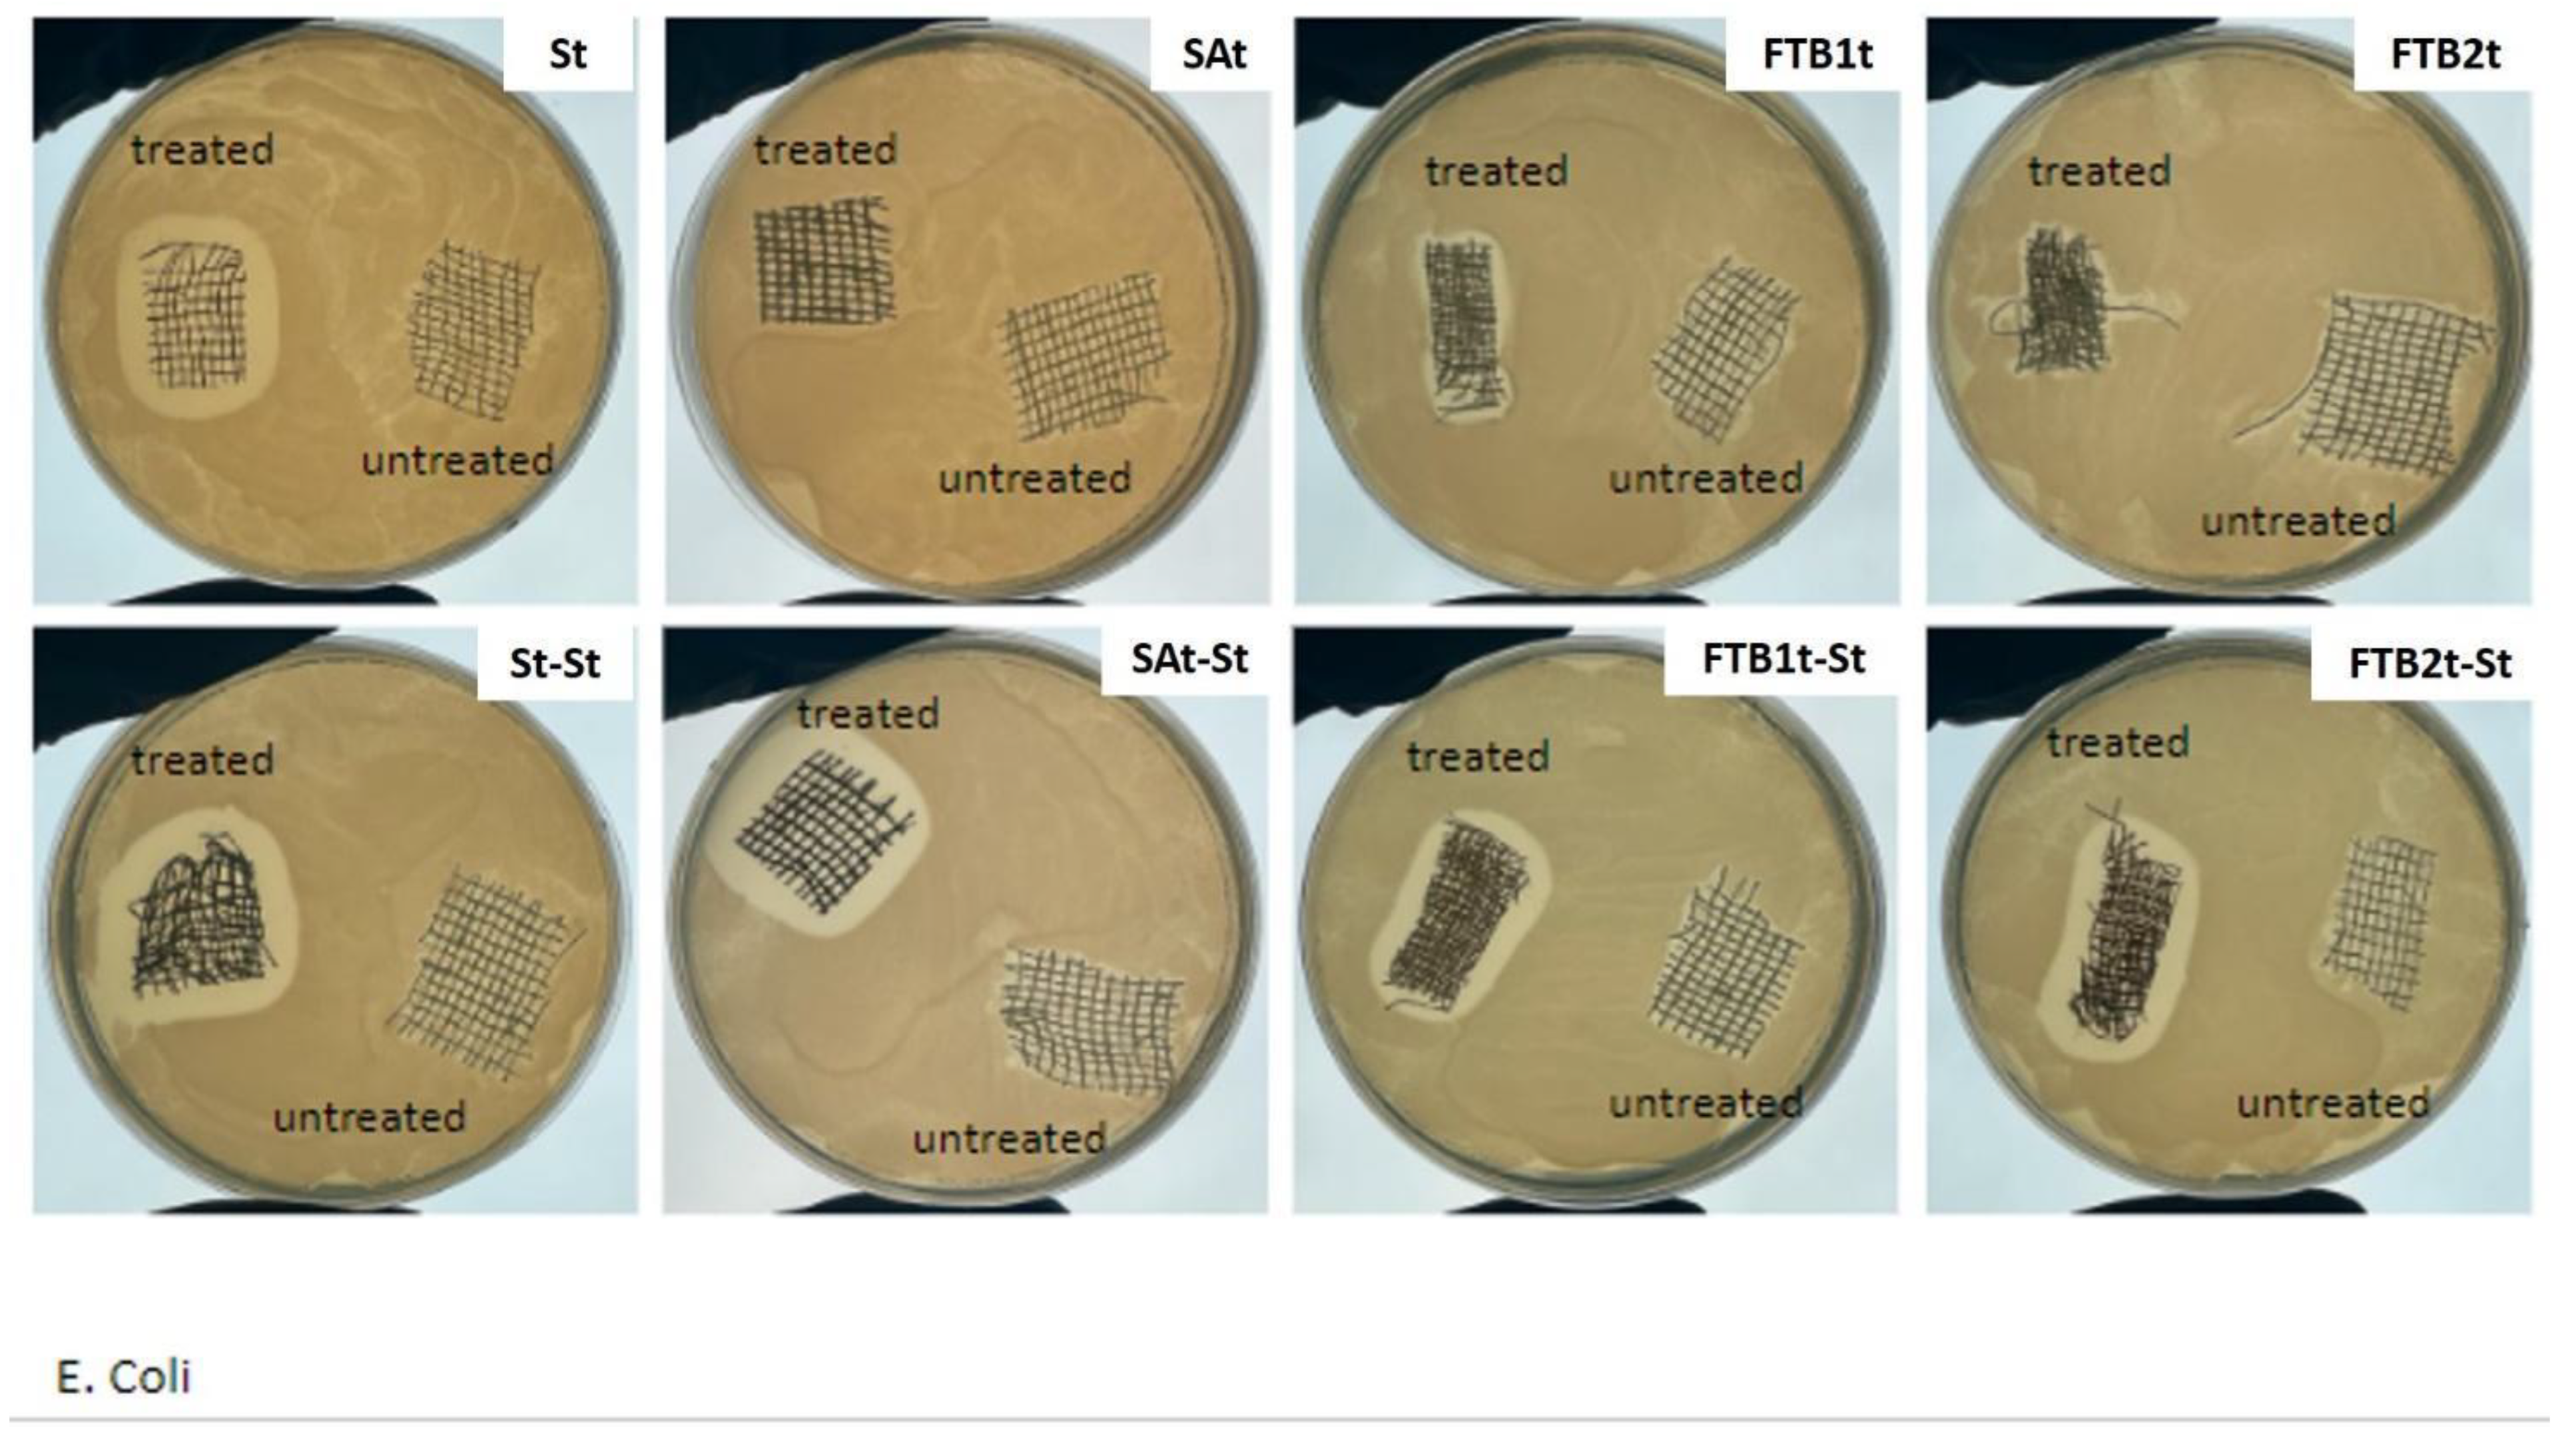

Nanotechnological Antibacterial and Conductive Wound Dressings for Pressure Ulcer Prevention
Abstract
1. Introduction
2. Materials and Methods
2.1. Preparation of the Samples
2.1.1. Silane-Ashes Coating Deposition Technology
2.1.2. Functionalized Torrefied Biomass Deposition Technology
2.1.3. Silver Deposition Technology
2.2. Characterization Techniques
2.2.1. Characterization of the Fillers
2.2.2. Characterization of the Gauze Specimens
3. Results and Discussion
4. Conclusions
Author Contributions
Funding
Data Availability Statement
Acknowledgments
Conflicts of Interest
References
- Livesley, N.J.; Chow, A.W. Infected pressure ulcers in elderly individuals. Clin. Infect. Dis. 2002, 35, 1390–1396. [Google Scholar] [CrossRef] [PubMed]
- Lin, Y.H.; Chen, Y.C.; Cheng, K.S.; Yu, P.J.; Wang, J.L.; Ko, N.Y. Higher periwound temperature associated with wound healing of pressure ulcers detected by infrared thermography. J. Clin. Med. 2021, 10, 2883. [Google Scholar] [CrossRef]
- Amrani, G.; Peko, L.; Hoffer, O.; Ovadia-Blechman, Z.; Gefen, A. The microclimate under dressings applied to intact weight-bearing skin: Infrared thermography studies. Clin. Biomech. 2020, 75, 104994. [Google Scholar] [CrossRef] [PubMed]
- Kottner, J.; Black, J.; Call, E.; Gefen, A.; Santamaria, N. Microclimate: A critical review in the context of pressure ulcer prevention. Clin. Biomech. 2018, 59, 62–70. [Google Scholar] [CrossRef] [PubMed]
- Yusuf, S.; Okuwa, M.; Shigeta, Y.; Dai, M.; Iuchi, T.; Rahman, S.; Usman, A.; Kasim, S.; Sugama, J.; Nakatani, T.; et al. Microclimate and development of pressure ulcers and superficial skin changes. Int. Wound J. 2015, 12, 40–46. [Google Scholar] [CrossRef] [PubMed]
- Sae-Sia, W.; Wipke-Tevis, D.D.; Williams, D.A. Elevated sacral skin temperature (Ts): A risk factor for pressure ulcer development in hospitalized neurologically impaired Thai patients. Appl. Nurs. Res. 2005, 18, 29–35. [Google Scholar] [CrossRef] [PubMed]
- Boyko, T.V.; Longaker, M.T.; Yang, G.P. Review of the Current Management of Pressure Ulcers. Adv. Wound Care 2018, 7, 57–67. [Google Scholar] [CrossRef] [PubMed]
- Gefen, A. The role of the thermal conductivity of dressings in prevention and treatment of wounds. Wounds Int. 2021, 12, 18–24. [Google Scholar]
- Lechner, A.; Rancan, F.; Hadam, S.; Vogt, A.; Blume-Peytavi, U.; Kottner, J. Comparing the effects of three different multilayer dressings for pressure ulcer prevention on sacral skin after prolonged loading: An exploratory crossover trial. Wound Repair Regen. 2021, 29, 270–279. [Google Scholar] [CrossRef]
- Cutting, K.; Gefen, A. PolyMem and Countering Inflammation Made Easy. Wounds Int. 2019, 1–6. [Google Scholar]
- Bhargava, A.; Chanmugam, A.; Herman, C. Heat transfer model for deep tissue injury: A step towards an early thermographic diagnostic capability. Diagn. Pathol. 2014, 9, 36. [Google Scholar] [CrossRef] [PubMed]
- Jain, M.; Shakya, M. Role of Thermal Conductivity in Temperature Variation during Wound Healing Process after Plastic Surgery. Int. J. Math. Comput. Model 2013, 18, 1114–1123. [Google Scholar]
- Uzun, M.; Anand, S.C.; Shah, T. Thermal Conformability of Developed Fibrous Wound Dressings. J. Text. Eng. Fash. Technol. 2017, 2, 261–264. [Google Scholar] [CrossRef][Green Version]
- Glicksman, L.R. Heat transfer in foams. In Low Density Cellular Plastics; Springer: Dordrecht, The Netherlands, 1994; pp. 104–152. [Google Scholar] [CrossRef]
- Pau, D.S.W.; Fleischmann, C.M.; Spearpoint, M.J.; Li, K.Y. Thermophysical properties of polyurethane foams and their melts. Fire Mater. 2014, 38, 433–450. [Google Scholar] [CrossRef]
- Singh, G.; Byrne, C.; Thomason, H.; McBain, A.J. Investigating the microbial and metalloprotease sequestration properties of superabsorbent wound dressings. Sci. Rep. 2022, 12, 4747. [Google Scholar] [CrossRef] [PubMed]
- Dana, A.N.; Bauman, W.A. Bacteriology of pressure ulcers in individuals with spinal cord injury: What we know and what we should know. J. Spinal Cord Med. 2015, 38, 147–160. [Google Scholar] [CrossRef]
- Si, H.; Xing, T.; Ding, Y.; Zhang, H.; Yin, R.; Zhang, W. 3D bioprinting of the sustained drug release wound dressing with double-crosslinked hyaluronic-acid-based hydrogels. Polymers 2019, 11, 1584. [Google Scholar] [CrossRef] [PubMed]
- Jia, Y.; Zhang, H.; Yang, S.; Xi, Z.; Tang, T.; Yin, R.; Zhang, W. Electrospun PLGA membrane incorporated with andrographolide-loaded mesoporous silica nanoparticles for sustained antibacterial wound dressing. Nanomedicine 2018, 13, 2881–2899. [Google Scholar] [CrossRef] [PubMed]
- He, J.; Shi, M.; Liang, Y.; Guo, B. Conductive adhesive self-healing nanocomposite hydrogel wound dressing for photothermal therapy of infected full-thickness skin wounds. Chem. Eng. J. 2020, 394, 124888. [Google Scholar] [CrossRef]
- Shi, W.; Song, N.; Huang, Y.; He, C.; Zhang, M.; Zhao, W.; Zhao, C. Improved Cooling Performance of Hydrogel Wound Dressings via Integrating Thermal Conductivity and Heat Storage Capacity for Burn Therapy. Biomacromolecules 2022, 23, 889–902. [Google Scholar] [CrossRef]
- Paladini, F.; De Simone, S.; Sannino, A.; Pollini, M. Antibacterial and Antifungal Dressings Obtained by Photochemical Deposition of Silver Nanoparticles. J. Appl. Polym. Sci. 2014, 131, 40326–40334. [Google Scholar] [CrossRef]
- Striani, R.; Stasi, E.; Giuri, A.; Seiti, M.; Ferraris, E.; Esposito Corcione, C. Development of an innovative and green method to obtain nanoparticles from carbon-based waste ashes. Nanomaterials 2021, 11, 577. [Google Scholar] [CrossRef] [PubMed]
- Giuri, A.; Striani, R.; Carallo, S.; Colella, S.; Rizzo, A.; Mele, C.; Bagheri, S.; Seiti, M.; Ferraris, E.; Esposito Corcione, C. Waste carbon ashes/PEDOT:PSS nano-inks for printing of supercapacitors. Electrochim. Acta 2023, 441, 141780. [Google Scholar] [CrossRef]
- Kiani, A.; Lamberti, E.; Viscusi, G.; Giudicianni, P.; Grottola, C.M.; Ragucci, R.; Gorrasi, G.; Acocella, M.R. Eco-friendly one-shot approach for producing a functionalized nano-torrefied biomass: A new application of ball milling technology. Mater. Adv. 2023, 5, 695–704. [Google Scholar] [CrossRef]
- Sportelli, M.C.; Picca, R.A.; Paladini, F.; Mangone, A.; Giannossa, L.C.; Di Franco, C.; Gallo, A.L.; Valentini, A.; Sannino, A.; Pollini, M.; et al. Spectroscopic characterization and nanosafety of Ag-modified antibacterial leather and leatherette. Nanomaterials 2017, 7, 203. [Google Scholar] [CrossRef] [PubMed]
- Paladini, F.; Sannino, A.; Pollini, M. In vivo testing of silver treated fibers for the evaluation of skin irritation effect and hypoallergenicity. J. Biomed. Mater. Res.-Part B Appl. Biomater. 2014, 102, 1031–1037. [Google Scholar] [CrossRef] [PubMed]
- Flynn, J.H.; Levin, D.M.A. A method for the determination of thermal conductivity of sheet materials by DSC. Thermochim. Acta 1988, 126, 93–100. [Google Scholar] [CrossRef]
- Das, A.; Alagirusamy, R.; Kumar, P. Study of heat transfer through multilayer clothing assemblies: A theoretical prediction. Autex Res. J. 2011, 11, 54–60. [Google Scholar] [CrossRef]
- Souza, J.M.; Henriques, M.; Teixeira, P.; Fernandes, M.M.; Fangueiro, R.; Zille, A. Comfort and Infection Control of Chitosan-impregnated Cotton Gauze as Wound Dressing. Fibers Polym. 2019, 20, 922–932. [Google Scholar] [CrossRef]
- Xia, J.; Kong, X.; Li, L.; Zhang, Z.; Chen, Y.; Li, M.; Qin, Y.; Cai, T.; Dai, W.; Fang, S.; et al. High Thermal Conductivity and Radiative Cooling Designed Boron Nitride Nanosheets/Silk Fibroin Films for Personal Thermal Management. ACS Appl. Mater. Interfaces 2024, 16, 7732–7741. [Google Scholar] [CrossRef]
- Reid, K.; Ayello, E.; Alavi, A. Pressure ulcer prevention and treatment: Use of prophylactic dressings. Chronic Wound Care Manag. Res. 2016, 3, 117–121. [Google Scholar] [CrossRef]
- Geng, J.; Cai, Y.; Lu, H.; Zhang, R.; Tian, J.; Zhang, J. Moist dressings in the treatment of pressure injuries: A network meta-analysis. J Tissue Viability 2023, 32, 213–227. [Google Scholar] [CrossRef] [PubMed]

| Sample | Thermal Conductivity (W/mK) |
|---|---|
| untreated gauze | 1.8 × 10−3 |
| gauze_SAt | 3.9 × 10−3 |
| gauze_FTBt1 | 1.3 × 10−3 |
| gauze_FTBt2 | 1.8 × 10−3 |
| gauze_St | 2.3 × 10−3 |
| gauze_St-St | 3.8 × 10−3 |
| gauze_SAt-St | 2.5 × 10−3 |
| gauze_FTBt1-St | 3.2 × 10−3 |
| gauze_FTBt2-St | 3.7 × 10−3 |
| Multilayer System | Thickness (m) | Total Thermal Resistance (k/W) | Total Thermal Conductivity (W/mK) |
|---|---|---|---|
| A | 8.4 × 10−4 | 2.7 × 10−3 | 3.1 × 10−1 |
| B | 1.0 × 10−3 | 3.4 × 10−3 | 2.9 × 10−1 |
Disclaimer/Publisher’s Note: The statements, opinions and data contained in all publications are solely those of the individual author(s) and contributor(s) and not of MDPI and/or the editor(s). MDPI and/or the editor(s) disclaim responsibility for any injury to people or property resulting from any ideas, methods, instructions or products referred to in the content. |
© 2024 by the authors. Licensee MDPI, Basel, Switzerland. This article is an open access article distributed under the terms and conditions of the Creative Commons Attribution (CC BY) license (https://creativecommons.org/licenses/by/4.0/).
Share and Cite
Pollini, M.; Striani, R.; Paladini, F.; Kiani, A.; Acocella, M.R.; Esposito Corcione, C. Nanotechnological Antibacterial and Conductive Wound Dressings for Pressure Ulcer Prevention. Nanomaterials 2024, 14, 1309. https://doi.org/10.3390/nano14151309
Pollini M, Striani R, Paladini F, Kiani A, Acocella MR, Esposito Corcione C. Nanotechnological Antibacterial and Conductive Wound Dressings for Pressure Ulcer Prevention. Nanomaterials. 2024; 14(15):1309. https://doi.org/10.3390/nano14151309
Chicago/Turabian StylePollini, Mauro, Raffaella Striani, Federica Paladini, Aida Kiani, Maria Rosaria Acocella, and Carola Esposito Corcione. 2024. "Nanotechnological Antibacterial and Conductive Wound Dressings for Pressure Ulcer Prevention" Nanomaterials 14, no. 15: 1309. https://doi.org/10.3390/nano14151309
APA StylePollini, M., Striani, R., Paladini, F., Kiani, A., Acocella, M. R., & Esposito Corcione, C. (2024). Nanotechnological Antibacterial and Conductive Wound Dressings for Pressure Ulcer Prevention. Nanomaterials, 14(15), 1309. https://doi.org/10.3390/nano14151309

